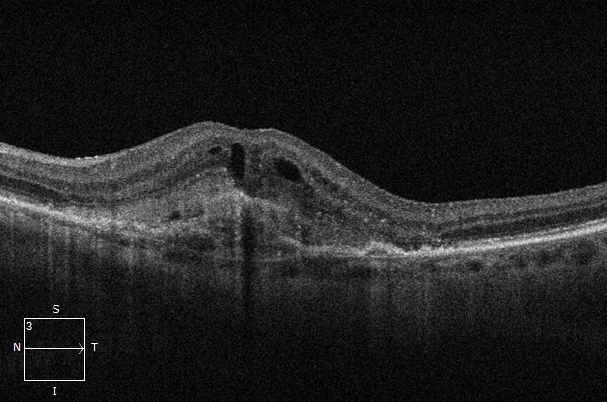

Diagnosestellung
In einer Spezialuntersuchung (Schichtaufnahme bzw. OCT; Farbstoffuntersuchung bzw. FAG) erfolgt eine genaue Diagnosestellung und Festlegung der Behandlung. In einem ausführlichen Arzt-Patienten-Gespräch besprechen wir mit Ihnen die Erkrankung. Je nach Augenkrankheit (zum Beispiel feuchte Makulaerkrankung) passt sich die Behandlung an die individuelle Form der Erkrankung an und es wird entsprechend anhand der aktuellsten Studien- und Forschungslage ein Therapieplan besprochen. Um ein Fortschreiten und Einwachsen von Gefäßen zu verhindern, ist das Einspritzen von Gefäß-Wachstum-Hemmern (anti-VEGF) notwendig (IVOM). Ohne Therapie schreitet die Erkrankung in der Regel rasch voran.
Bei folgenden Erkrankungen kann eine Therapie notwendig sein:
- feuchte Makulaerkrankung (AMD)
- Netzhauterkrankung durch Zuckerkrankheit (Diabetes)
- Gefäßverschluss in der Netzhaut
- Gefäßneubildung im Rahmen einer Zweiterkrankung.
Genauere Informationen zu den einzelnen Erkrankungen erhalten Sie auf unserer Seite mit den Patienteninformationen.
Am Tag der Spritze
Bitte Tragen Sie bequeme Kleidung und verzichten Sie auf Schminke. Falls Blutverdünner eingenommen werden, müssen diese NICHT abgesetzt oder umgestellt werden.
Nach Anmeldung in unserer OP-Praxis erfolgt direkt vor jeder Einspritzung in den Glaskörper eine Untersuchung durch die Schwestern und das ärztliche Personal (inkl. einer Überprüfung des Therapieplans). Die Behandlung erfolgt nach örtlicher Betäubung mit speziellen Augentropfen und dauert 2-3 Minuten, wobei der nahezu schmerzfreie Einstich mit der sehr dünnen Spezialnadel nur wenige Sekunden dauert. Direkt nach dem Eingriff wird das Auge mit antibakterieller Augensalbe versorgt, um das Entzündungsrisiko zu senken. Zur Linderung möglicher Beschwerden wie einem Druck am Auge oder Kratzen empfiehlt es sich, nach der OP bei Bedarf künstliche Tränen (Tränenersatzmittel) zu tropfen.
Nachuntersuchung
Die Kontrolle erfolgt innerhalb der ersten 4 Tage nach der Operation bei Ihrem Augenarzt oder Ihrer Augenärztin.
Zusammenarbeit
Wir stehen ständig in engem Kontakt mit Ihrem behandelnden Augen- und Hausarzt. Sowohl über die Diagnosestellung als auch jeden operativen Eingriff informieren wir unsere Kollegen/-innen ausführlich mit einem Arztbrief. Mögliche Rückfragen können wir in den allermeisten Fällen über einen kurzen telefonischen Kontakt klären.
Notfall
Beschwerden nach einer IVOM sind äußerst selten. Sollten unerwartet starke Schmerzen, eine Rötung und/oder eine Sehverschlechterung nach einer Injektion auftreten, bitten wir um sofortige Vorstellung beim Augenarzt/-ärztin oder Kontaktaufnahme mit dem Kassenärztlichen Notdienst unter 116 117.
Galerie
Entwicklung nach 2 Medikamenteneinspritzungen im Augenzentrum Gera am Elsterufer. Auf dem Netzhautfoto (Abb. 1) und dem Makula-OCT VOR der Behandlung (Abb. 2) ist ein typischer Befund der feuchten AMD zu sehen. Im Makula-OCT derselben Netzhaut (Abb. 3) ist NACH 2 Spritzen ein deutlicher Rückgang der Aktivität zu erkennen. Zum Vergleich zeigt Abb. 4 eine gesunde Netzhaut.
x